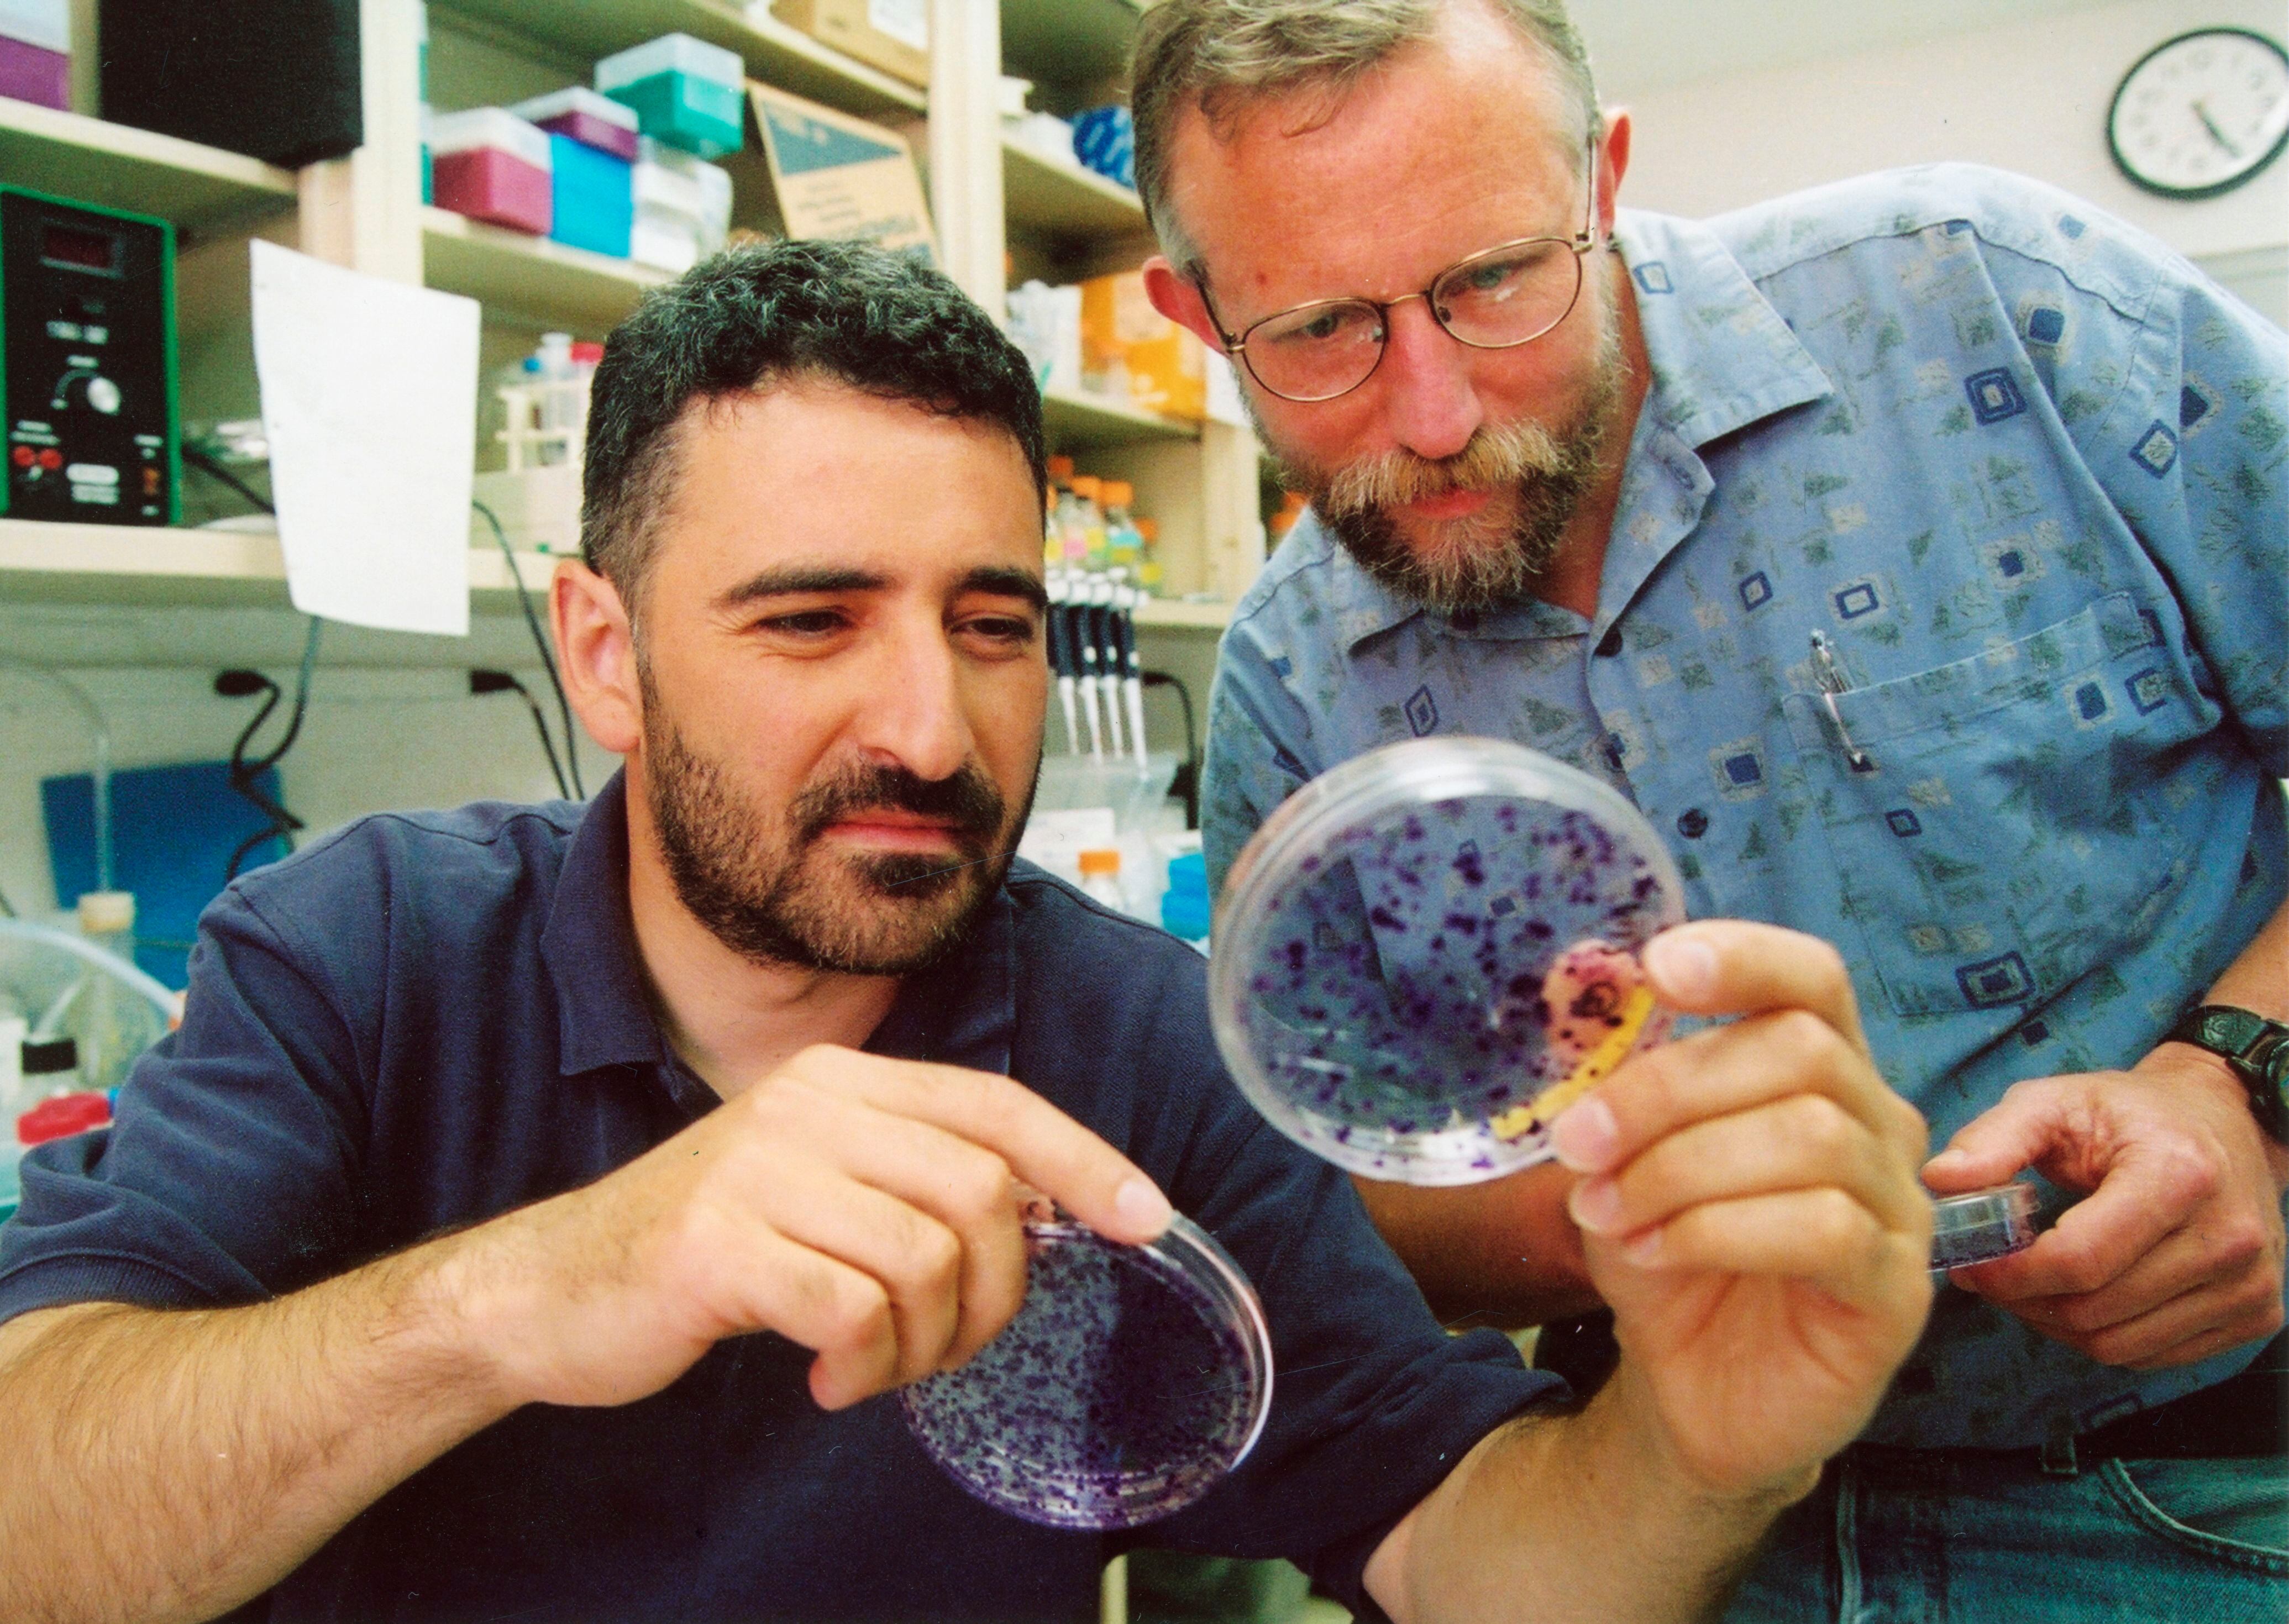

Estocolmo. En plena pandemia de covid-19, el premio Nobel de Medicina fue atribuido el lunes a los estadounidenses Harvey Alter y Charles Rice y al británico Michael Houghton por el descubrimiento del virus responsable de la hepatitis C.
Los tres virólogos fueron galardonados por “su decisiva contribución a la lucha contra esta hepatitis, un importante problema de salud mundial, que causa cirrosis y cáncer de hígado”, explicó el jurado del Nobel, en plena carrera mundial para hallar los secretos de otra pandemia viral, la del covid-19.
“Espero que este premio, junto con la terrible epidemia de covid, destaque la importancia de la virología para la humanidad”, destacó Houghton. “Esto puede afectar a muchos de nosotros”, dijo el ganador de 69 años, en una entrevista en Zoom.
A finales de los años 1970, Harvey Alter, quien hoy tiene 85 años, identificó que durante las transfusiones tenía lugar un contagio hepático misterioso, y no era ni hepatitis A ni hepatitis B, señaló el jurado.
Años más tarde, en 1989, se le atribuyó a Houghton y su equipo el descubrimiento de la secuencia genética del virus.
En cuanto a Charles Rice, de 68 años, “aportó la prueba final de que el virus de la hepatitis C podría causar por si solo la enfermedad”, precisó Patrick Ernfors, el presidente del comité que elige a los premiados. Analizó igualmente durante años la manera en la que el virus se replicaba.
“Lo primero que hay que hacer es identificar el virus implicado, y una vez hecho, es el punto de partida para el desarrollo de tratamientos de la enfermedad, así como vacunas. Por lo que el descubrimiento viral es un momento crítico”, agregó.
Rice se manifestó “optimista” sobre el futuro de la lucha contra el virus y la covid-19.

“Creo que esto nos ha enseñado mucho sobre la ciencia en general: cuando hay un problema acuciante y se moviliza a la gente en todo el mundo para trabajar en estos problemas, se puede hacer un gran progreso”, aunque “no es posible” esperar “un tratamiento o una vacuna en una semana”, comentó.
La Organización Mundial de la Salud (OMS) estima en unos 70 millones el número de infecciones por la hepatitis C, que causa 400.000 muertes al año, incluso si en los últimos años se han desarrollado tratamientos eficaces, aunque muy costosos.
“¡Es el mejor despertador que he tenido!”, celebró el galardonado Harvey Alter, quien contó que al ser las 4:30 a. m. lo despertaron las llamadas de la Fundación Nobel, antes de finalmente responder a la tercera.
“Es algo que piensas que nunca va a suceder (...) y finalmente sucede”, declaró a la Fundación Harvey Alter, quien con 85 años se convierte en uno de los premiados más longevos del Nobel de Medicina. El récord se sitúa en los 87 años.
El reconocimiento es el primero directamente relacionado a un virus desde el 2008. En 1976, el Nobel fue para las investigaciones sobre la hepatitis B.
Son ya 222 los laureados con el premio de “Fisiología o de Medicina” desde su creación, entre los que figuran únicamente 12 mujeres.
Desde el hallazgo hace más de medio siglo de dos tipos de linfocitos, B y T, esenciales en la comprensión de nuestro sistema inmunitario, hasta el avance de las “tijeras moleculares” en genética en los años 2010, pasando por investigaciones del cáncer de mama, varios grandes descubrimientos médicos -y sus autores- fueron citados por los expertos como potenciales galardonados con el Nobel este año.
Otros científicos fueron mencionados por sus trabajos sobre la hepatitis C, el alemán Ralf Bartenschlager por la investigación fundamental, y el estadounidense Michael Sofia por el desarrollo del sofosbuvir, que el laboratorio Gilead vende ahora a precio de oro con el nombre de Sovaldi.
Próximos galardones
El año pasado, el Nobel de Medicina recompensó a los estadounidenses Willial Kaelin y Gregg Semenza, así como al británico Peter Ratcliffe, especialistas del impacto del oxígeno sobre las células.
Los Nobel de 2020 se anuncian como estaba previsto esta semana, pero el coronavirus ha provocado la anulación de la ceremonia presencial de entrega el 10 de diciembre en Estocolmo, por primera vez desde 1944.
Los laureados, que comparten cerca de un millón de euros (1,17 millones de dólares), recibirán sus galardones en sus países de residencia.
Esta edición 2020 de los Premios Nobel continúa el martes con el de Física y el miércoles con el de Química, el de Literatura el jueves y el de la Paz el viernes.
